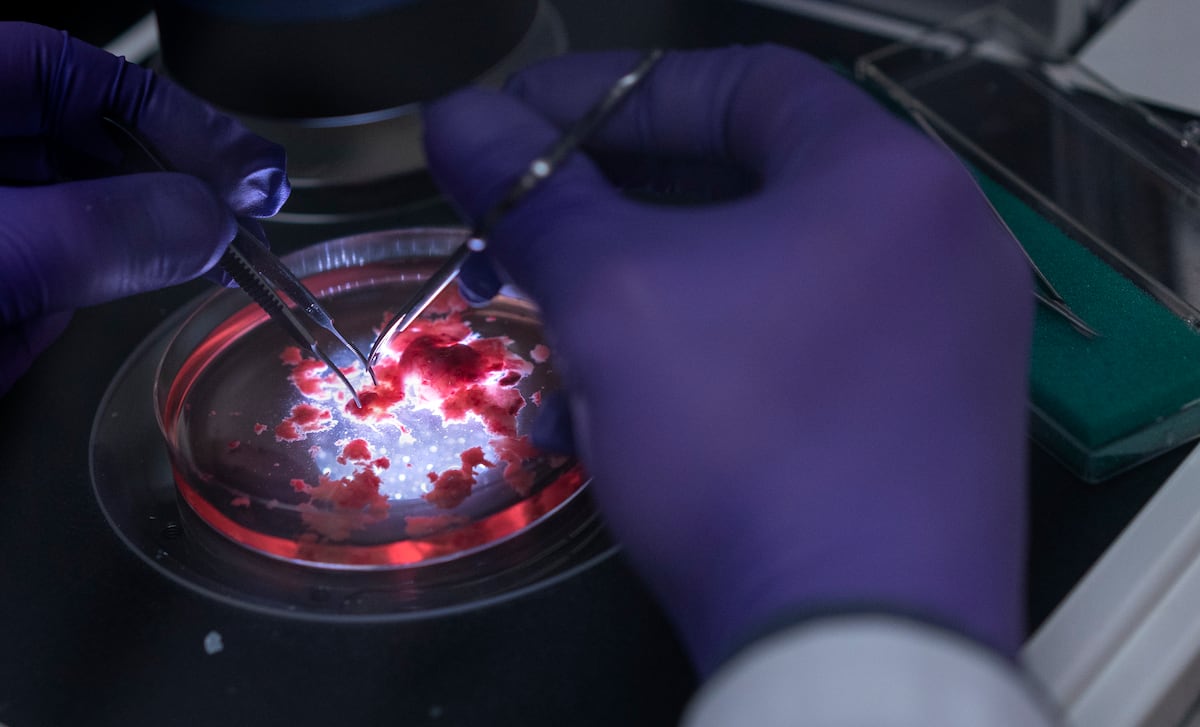

Alerta meteorológica para el fin de semana
La AEMET ha anunciado que el sábado y el domingo se producirá un cambio radical del tiempo en gran parte de España. Las máximas pasarán de casi 30 °C el viernes a menos de 10 °C el domingo, y se activarán avisos naranja y amarillo por oleaje, lluvias, tormentas y nevadas en varias comunidades. Este abrupto descenso pondrá a prueba a la población y a los servicios de emergencia.
Detalles de los avisos y evolución del frente frío
El aviso naranja por oleaje se emitió para la costa de A Coruña el sábado y se amplió el domingo a Asturias, Cantabria, Bizkaia y Girona. En Galicia, Pontevedra, Lugo y en la zona de Melilla se mantiene el aviso amarillo por oleaje. Avisos amarillos por lluvias y tormentas cubren Ávila, Segovia, Córdoba, Granada, Jaén y Sevilla, mientras que los amarillos por nieve afectan a Burgos, Soria, Navarra, La Rioja y, a partir del domingo, a Lleida. El viento sigue bajo alerta amarilla en Zaragoza.
El frente frío llega desde el oeste y avanza de oeste a este sin tocar el Mediterráneo. Las precipitaciones serán más intensas en el Cantábrico y en la zona montañosa del norte y centro, con la mitad sur experimentando chubascos tormentosos. La cota de nieve descenderá a 700‑800 m en el norte y centro peninsular, y la sensación térmica se verá agravada por vientos fuertes.